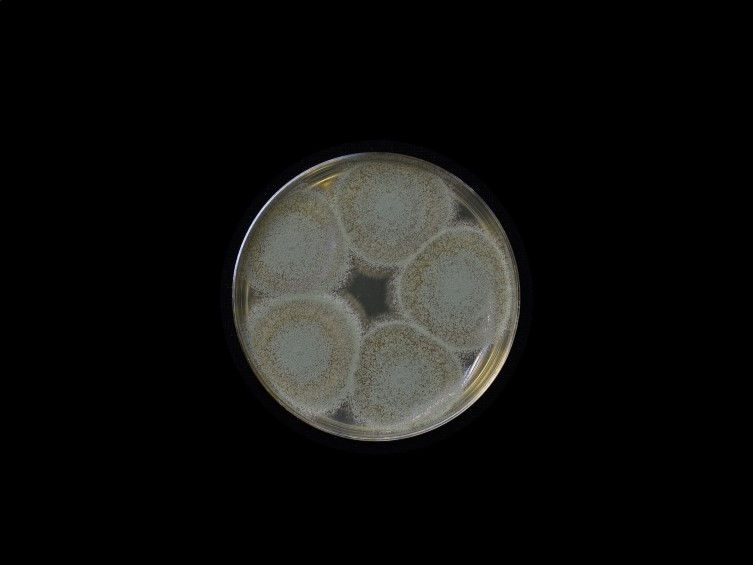

Holotype:
THAILAND, Namtok Samlan National Park, 2 Feb. 2005, J. Luangsa-ard, S. Mongkolsamrit, holotype BBH 14640, ex-type living culture BCC 17091.
Habitat:
Underside of bamboo leaves.
Host:
Leafhoppers (Hemiptera, Cicadellidae).
Description:
 Host head and thorax covered with pale green to green mycelium covered by sporulating conidiophores.
Host head and thorax covered with pale green to green mycelium covered by sporulating conidiophores.
Culture characteristics:
Colonies on PDA at first white turning green due to conidiation after 3 d. Vegetative hyphae are hyaline and smooth walled, forming a basal felt bearing densely packed, erect conidiophores and often having a floccose marginal overgrowth of aerial mycelium. Conidiophores erect, resembling Nomuraea in forming dense clusters of branches, each bearing 2–4 globose to subglobose conidiogenous cells without a distinct neck, around the stalk.
Colonies on PDA at first white turning green due to conidiation after 3 d. Vegetative hyphae are hyaline and smooth walled, forming a basal felt bearing densely packed, erect conidiophores and often having a floccose marginal overgrowth of aerial mycelium. Conidiophores erect, resembling Nomuraea in forming dense clusters of branches, each bearing 2–4 globose to subglobose conidiogenous cells without a distinct neck, around the stalk.  Phialides are short and cylindrical, 5–7 × 2–3 μm.
Phialides are short and cylindrical, 5–7 × 2–3 μm.  Conidia globose, 3–4 μm in diam.
Conidia globose, 3–4 μm in diam.
Reference:
Luangsa-ard JJ, Mongkolsamrit S, Thanakitpipattana D, et al. (2017). Clavicipitaceous entomopathogens: new species in Metarhizium and a new genus Nigelia. Mycological Progress 16: 369–391.
DOI: https://doi.org/10.1007/s11557-017-1277-1Species |
Strain |
Compound |
Pubchem CID |
Biological activity |
Reference |
|---|
|
Strain |
LSU | RPB1 | RPB2 | SSU | TEF1 |
|---|---|---|---|---|---|
| BCC 17091 | HQ165727 | - | HQ165646 | HQ165665 | HQ165686 |
| BCC 17093 | HQ165728 | HQ165746 | HQ165647 | HQ165666 | HQ16568 |